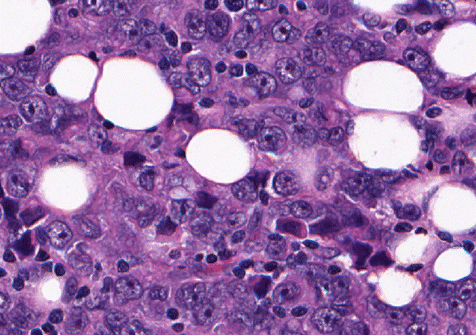
33410_qold_1952.gif

微信扫一扫联系


Dynamyx于今年3月获得了FDA批准,允许使用全玻片图像(WSI)代替传统的载玻片进行初步诊断。据公司介绍Dynamyx是首个也是唯一一个获得FDA批准的具有多个扫描仪的数字病理学软件,并且还是全球唯一一个真正的开放、与供应商无关的端到端数字病理学解决方案。
这项交易预计于2023年初完成,协议的条款尚未披露。
病理人工智能存在着广阔的需求,随着AI等数字工具的发展,已经有越来越多巨头加码这一领域,比如此前阿里和腾讯都合作开发了病理AI平台,显示出巨大的发展潜力。
被富士胶片收购后,Dynamix将被纳入富士胶片Synapse企业级成像产品组合中。
作为一个完全开放的数字病理平台,Dynamix能够与各种实验室扫描仪兼容,同时允许构建和测试用户自己的图像分析算法。

Dynamix平台将病理载玻片进行数字化管理,允许远程实时协作进行诊断,获得诊断意见或完成线上培训教学。
Dynamix平台可以智能化地分配工作,增强实验室工作效率,减少积压样本。数字化管理也消除了运输病理切片需要消耗的成本和时间。
Dynamix人工智能阅片功能可以实现自动计数和测量算法(即 IHC 染色),诊断支持算法(即有丝分裂事件和恶性肿瘤检测)、预后流程(即远处转移的风险)、预测算法(即特定治疗设计的好处)、多模态融合算法(即辐射/路径/摩尔组合)等功能,极大减轻实验室的工作负担。
富士胶片表示,Dynamix即将加入“市场上最全面的企业成像产品组合之一”。自三年前与Inspirata在欧洲建立合作伙伴关系以来,已经在多家医疗机构中获得了巨大的成功,尤其是在英国。还表示:“我们收到了来自客户的反馈,数字化病理学是最具变革性的事项之一,我们期待将继续在全球实现扩张。”
而Inspirata在出售Dynamix平台后将更加专注于肿瘤信息学的研发,向着成为基于云的肿瘤信息学软件服务(SaaS)解决方案的领先提供商的战略定位进发。目前肿瘤信息学领域的关键工作流程,如临床试验匹配和癌症登记报告和数据抽象技术已经成熟,未来可以通过Inspirata开发的强大的AI和NLP(自然语言处理)技术实现该领域的颠覆。
1934年创立以来,作为一家摄影胶片制造商,富士胶片被全球消费者所熟知。伴随着数字化的到来,2000年以后,全球对摄影胶片的需求急剧下降。而胶片市场的萎缩和数码时代的到来产生了商业史上的两个经典案例。一是柯达的破产,一是富士胶片的“成功转身”。

这家胶片时代的巨头,在千禧年之后启动了公司的全面转型,并成功撕下胶片这一标签,逐步转型为以医疗健康、高性能材料和文件处理等为核心业务的“新巨头”。
富士胶片在医疗健康领域的优势在于,公司早在1936年就推出了医疗胶片,在医疗健康领域有非常悠久的历史,并且积累了丰富的技术经验。继1936年研发医用X光胶片之后,1980年代富士胶片开发了FCR(Fuji Computed Radiography),成为了第一个将X线图像数字化的公司。

在这一背景之下,富士胶片逐步扩展其影像诊断设备产品组合。2021年3月底,宣布收购日立公司的影像诊断相关业务,将整体医疗业务扩展至CT、MRI、X线摄影系统、超声诊断设备、内镜、体外诊断系统和PACS等广泛的产品线,覆盖并丰富了该公司在预防、诊断、治疗三大领域的产品。
在数字医疗领域,富士胶片于1999年将Synapse医学影像信息管理系统引入市场,将互联网信息技术与医学成像诊断系统结合在一起。这一强大的软件还可以通过扩展,利用云服务帮助实现分级诊疗,消除地域间医疗资源的不均衡。

经过多年的发展扩充,富士胶片Synapse系列产品包括:SYNAPSE VNA医学影像数据平台、“富医睿影”云胶片系统及SYNAPSE 3D三维影像后处理系统、SYNAPSE PACS 5等全线医疗信息化解决方案,在国内多家医院落地。
据富士胶片透露,目前富士胶片的SYNAPSE产品在全球PACS(影像归档和通信系统)市场中所占份额最大,已具有压倒性的竞争优势。
此次将Dynamix数字病理平台纳入SYNAPSE系列,也是进一步完善了产品序列,向巨大的人工智能病理学市场扩张。
人工智能和机器学习软件作为病理学领域的一种新工具,因其有效率和准确性的不断提高,越来越引起人们的重视。目前其市场应用正在不断扩大,根据Allied Market Research公司的市场调研,预计到2026年这一技术的市场总额将达到860万美元。
病理诊断是绝大部分疾病尤其是癌症诊断的金标准,然而传统病理阅片需要耗费大量的时间与精力,病理医生往往没有时间对每一张病理切片进行反复分析、计数,并且随着肿瘤发病率的日益上升,病理诊断的工作面临着巨大挑战。
病理症断需求高涨而病理医生不足的现状在国内尤其凸显。
2022年2月,国家癌症中心发布最新一期全国癌症统计数据:2016年中国恶性肿瘤发病人数为406.4万人,比世界平均高了67.66%。此外,由于恶性肿瘤发病率随年龄增加逐渐上升,而中国老龄化进程加剧,中国患癌人数持续增加。

数据来源:来自公开信息
按照原国家卫生部2009年发布的《病理科建设与管理指南(试行)》中规定的“二级、三级医院均需设置病理科,每100张床位需配置1-2名病理医师”标准计算,截止2021年末,病理医师需求量约为14.17万人,而现有病理医师仅2.1万人,中国病理医师缺口高达12万人。

资料来源:来自公开信息
并且由于病理检验的自动化水平较低,开展病理检验所需的时间较长。常规的病理检验所需时间至少在3天以上,如果有较为疑难的病症,加做免疫组化或分子病理,所需的诊断时间达7-10天。相比之下,检验、影像科室的检验项目大部分在当天即可完成。
而以AI为代表的新兴计算机算法恰好可补足此短板,为病理诊断发展带来新的飞跃,具有广阔的发展前景。
Inspirata
Inspirata就是这一领域的先驱。公司成立于2013年,开发了一个端到端的数字病理工作流解决方案,将玻璃病理切片扫描然后数字化,形成可用于高清晰观察和分享到全世界的数字图像。

据报道,Inspirata病理分析软件采用一种先进的称为Companion Diagnostics的图像分析算法,它可以对玻璃病理切片的数字图像上的可疑细胞区域进行预先扫描并将其标记出来,这可以帮助病理医生做出更快的诊断,让癌症检测和诊断的时间周期将从12 - 13天缩短到2 - 3天。
2018年Inspirata还收购了GE医疗与微软合资建立的医疗业务子公司恺恩泰(Caradigm)以加速其癌症信息数据库(CIDT)的发展。
飞利浦医疗
飞利浦医疗也是该领域的代表性企业。2017年旗下Intellisite病理解决方案软件(Philips IntelliSite Pathology Solution,PIPS)获得了FDA批准,成为第一个用于帮助解读数字病理图像的全视野图像系统( whole slide imaging,WIS)。
该系统基于约2000例手术病理切片的临床研究,包括了来自身体多个解剖部位的活检组织病理数据。研究结果发现,基于PIPS图像做出的病理诊断与使用显微镜直接观察载玻片作出的病理诊断准确性相当。
腾讯、阿里入局国内发展前景巨大
国内的病理人工智能领域也同样发展得如火如荼,不少科技巨头都加入了战局。比如,腾讯与专业的第三方病理检测企业华银健康合作,而阿里健康与兰丁高科等12家医疗健康AI企业共同建立了第三方人工智能开放平台。
该领域也在近几年的备受资本青睐。

数字与智慧病理领域最新融资事件一览 数据来源:蛋壳研究院
那么未来,病理人工智能还将实现哪些突破,能否实现病理检测的大规模替代,器械之家会持续关注。
转载自器械之家